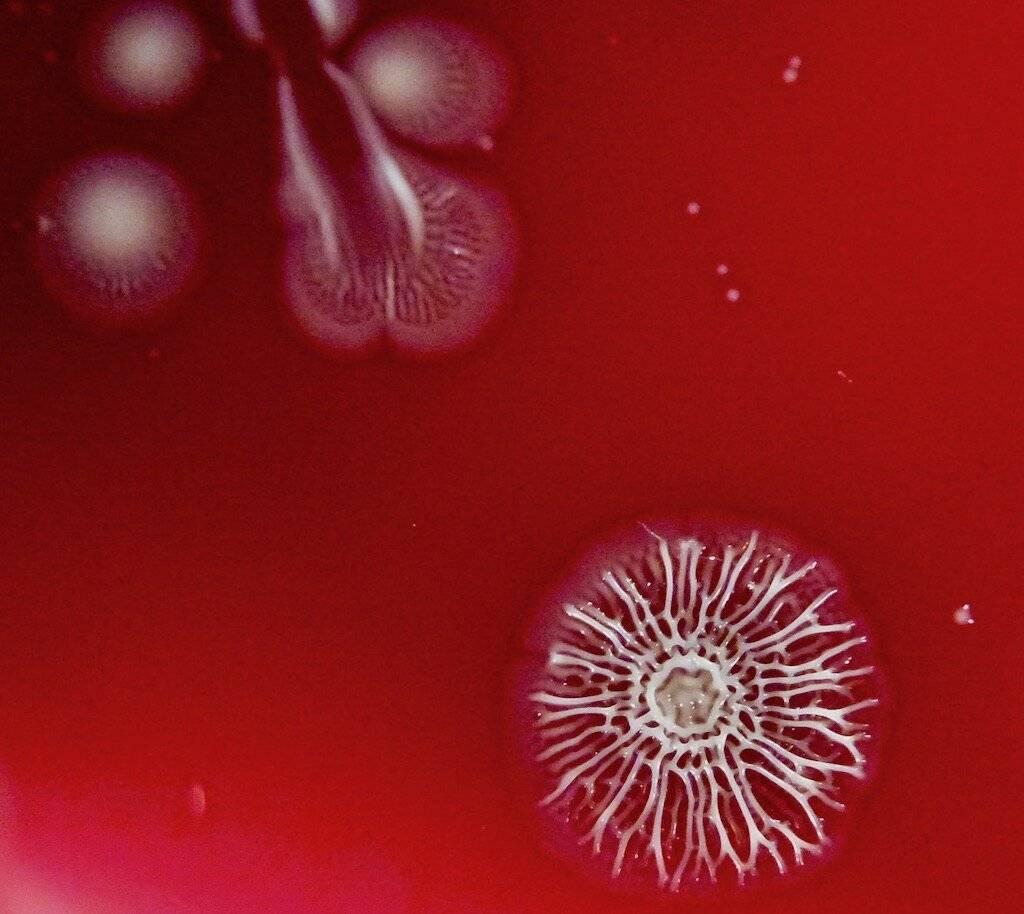
Colonies bactériennes, visibles, elles, à l’oeil nu : des milliards de bactéries échafaudent cette étrangeté.

Le premier qui voit la vérité
Antonie van Leeuwenoek est né en 1632 en Hollande. Il est drapier, et se familiarise avec les loupes pour apprécier la qualité des tissus. Qui sont tous encore en laine à cette époque. En amateur, il perfectionne peu à peu ses instruments, jusqu’à imaginer ce qu’on a appelé plus tard l’ancêtre du microscope. On pourrait appeler le XVII ième siècle, celui des lentilles, avant le XVIII ième siècle, celui des lumières, car c’est peu avant, en 1610, que Galilée bricole des lunettes hollandaises suffisamment puissantes pour qu’on puisse les appeler astronomiques.
Très rapidement, Antonie se met à regarder à côté de ses tissus.
Partout à côté.
Il taille lui même ses lentilles, avec un procédé jamais publié, et donc resté secret. Ses instruments lui permette de distinguer des détails de un micron : un millième de millimètre, donc un millionième de mètre : c’est l’ordre de grandeur de la taille des bactéries, c’est donc le premier homme à les avoir vues.
L’organe créé-t-il la fonction ? D’une curiosité devenue inlassable, un émerveillement renouvelé à la découverte « des créatures du Seigneur », suivant les mots de l’époque, il passera le reste de sa vie à observer. Ne se jugeant pas bon dessinateur, il laissera à d’autres le soin de dessiner ces nouvelles images.
Il correspondra pendant 50 ans à la Royal Society of London.
Quand il aperçoit des spicules sur les grains de poivre, il y voit l’origine de son gout !
Il publie une observation fracassante pour l’époque : des animalcules nageant dans une goutte d’eau de pluie, ce qu’on appellera plus tard des Protozoaires. L’anglais Robert Hooke, une sommité de l’époque, après bien des difficultés techniques, le confirme.
En 1677, il voit les spermatozoïdes dans le sperme, et il pense qu’ils sont là pour féconder un œuf femelle… Pas mal !
Il observe longuement les plaques dentaires, la sienne comme celles de ses proches. Il y décrit des minuscules anguilles, d’autant plus nombreuses que les bouches sont négligées. Les bactéries, de formes diverses, se déplacent parfois de manière ondulante… Il aime faire partager ses découvertes : certains sont dégoutés à la vue de ces minuscules bestioles grouillantes, d’autres sont étonnés autant qu’émerveillés…
En 1681, il décrit les Giardia qui restent actuellement les parasites les plus communs dans le monde, malgré les grands progrès dans la gestion des excréta.
A cette époque, les politiques sont très respectueux des scientifiques, fussent-ils amateurs. Leeuwenhoek accueillera chez lui le tsar Pierre Legrand, la reine d’Angleterre, Marie Stuart, Frédéric de Prusse !
Spinoza est un admirateur de ses travaux, et apprend à tailler les lentilles avec lui. C ‘est l’époque de Rembrandt, de Vermeer, qui est son ami, et dont il sera l’exécutaire testamentaire.
En 2019, c’est la notion de microbiote buccal qui se construit à coups d’analyses ADN, après le microbiote digestif, vaginal, cutané, pulmonaire …
Certaines bactéries sont pointées du doigt, d’autres manquent à l’appel pour une bonne santé dentaire et gingivale, tels les bienveillants Lactobacillus.
Dans la maladie parodontale, complexe, on observe les bactéries dites Anaérobies à l’œuvre, accompagnées même de Protozoaires, des Amibes –Entamoeba gingivalis-ronger des tissus en fâcheux état.
On parle de toxines, les gingipaïnes, promues récemment co-facteur de la maladie d’Alzheimer. Secrétées par les Porphyromonas gingivalis, elles confortent ces dernières dans le rôle d’emmerdeuses notoires, retrouvées en grand nombre dans certaines bouches.
Mais reste qu’il est très difficile de faire le tri entre terrain favorable, voire génétique, immunité défaillante, hygiène sommaire, et agressivité bactérienne !
Si Antonie est le père des microscopistes de tous poils, c’est une berlinoise, Martha Wygodzinski, qui est la première femme bactériologiste en Allemagne. Née en 1869, c’est en Suisse qu’elle ira étudier la médecine, la faculté étant interdite aux femmes en Allemagne à cette époque. Elle fut appelée « l’ange des pauvres », s’étant consacrée au début de sa carrière aux femmes indigentes. Elle créa plus tard le premier laboratoire de Berlin. Sa licence lui fut enlevée en 1936 par les nazis, et elle mourut d’épuisement au ghetto de Theresienstadt en 1942.